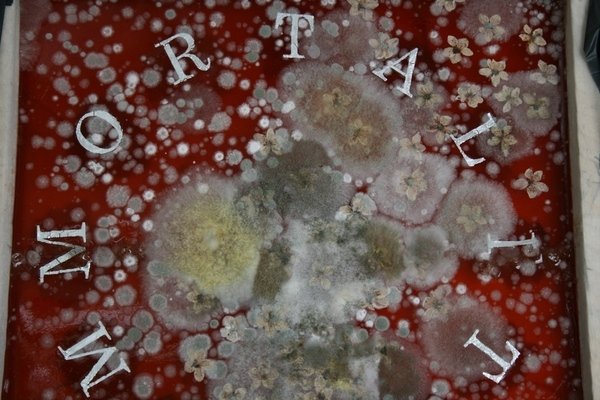
Detail of Immortality by Charlie Millar
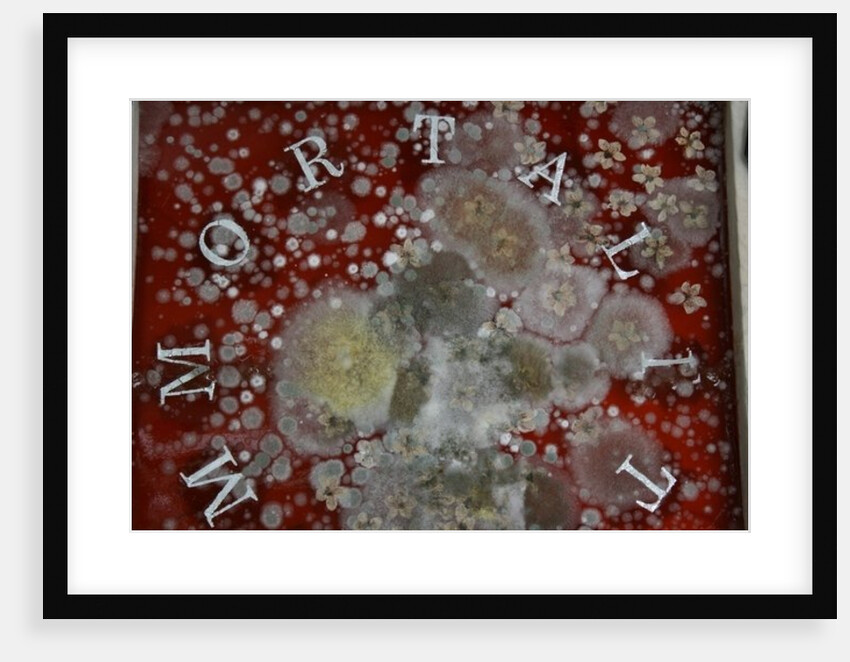
Immortality by Charlie Millar
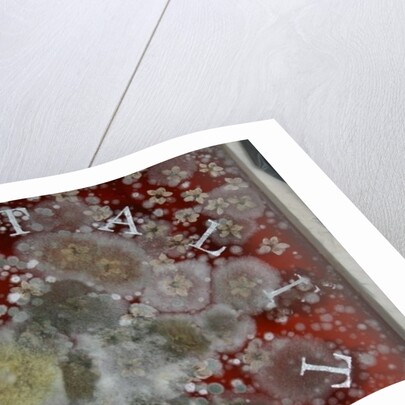
Immortality by Charlie Millar
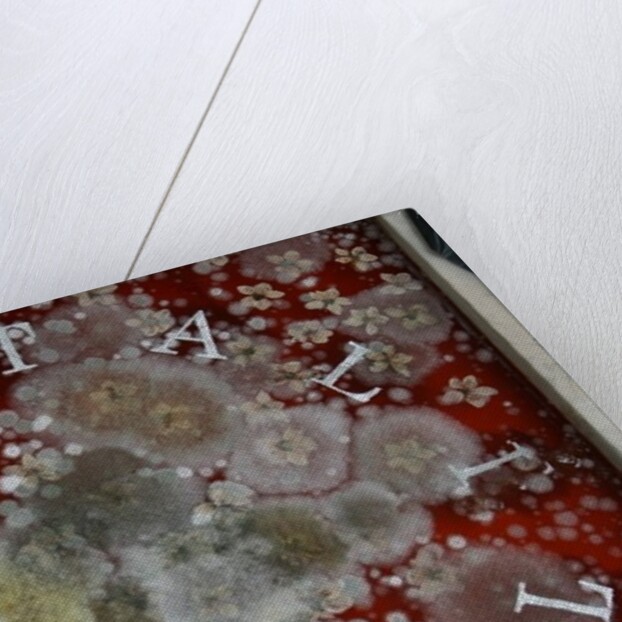
Immortality by Charlie Millar
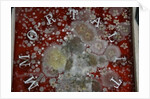
Immortality by Charlie Millar
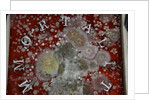
Immortality by Charlie Millar

Sizing information
| Overall size (inc frame) | x cm ( x in) |
| Depth | cm (in) |
| Artwork | x cm ( x in) |
| Border (mount) |
cm
top/bottom
(in)
cm left/right (in) |
| The paper size of our wall art shipped from the US is sized to the nearest inch. | |

Our framed prints
Every framed picture is created by hand in our workshop by specialist framers.
Black, white, silver, gold or natural frames available, supplied ready to hang.
All our frames have a smooth satin finish, and measure 20mm (front face) by 23mm (depth from wall).
Read more about our framed art prints.
Manufactured in the UK, the US and the EU
All products are created to order in our print factories around the globe, and we are the trusted printing partner of many high profile and respected art galleries and museums.
We are proud to have produced over 1 million prints for hundreds of thousands of customers.
Delivery & returns
We print everything to order so delivery times may vary but all framed pictures are despatched within 3 days.
Delivery to the UK, EU & US is free when you spend £75. Otherwise, delivery to the UK costs £10 for a single framed print.
We will happily replace your order if everything isn’t 100% perfect.
Product images of Immortality


Product details Immortality
Find related images
zoom
zoom